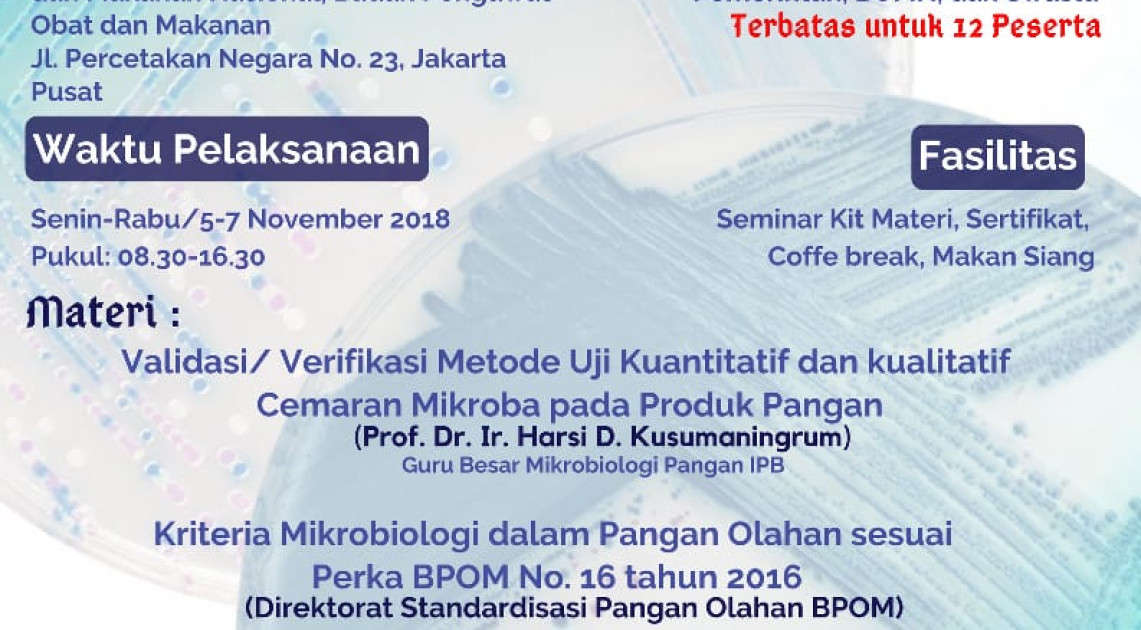
PPPOMN

Pengawasan Post Market melalui Sosialisasi Pedoman Penanganan Keracunan untuk Tenaga Kesehatan
07 Oct 2018 Dilihat 3553 kali Pusat Data dan Informasi Obat dan MakananPengawasan obat dan makanan menjadi tugas utama Badan POM yang bertujuan untuk memberikan jaminan atas keamanan, manfaat atau khasiat dan mutu produk obat dan makanan yang beredar. Salah satu upaya Badan POM dalam mereal...
Selengkapnya
Pelatihan Validasi/ Verifikasi Metode Uji Kuantitatif dan Kualitatif Cemaran Mikroba pada Produk Pangan
05 Oct 2018 Dilihat 6007 kali PPPOMNValidasi dan verifikasi metode memiliki nilai penting dalam pengujian, merupakan persyaratan utama dalam akreditasi mutu ISO/SNI 17025 untuk laboratorium pengujian. Metode yang tervalidasi atau terverifikasi akan menjami...
SelengkapnyaPeserta Job Fair di Makassar Membeludak
05 Oct 2018 Dilihat 2769 kali Kerjasama dan HumasMakassar – Salama’ki tapada salama’, job fair dalam rangka pencarian dan penyaringan SDM yang tangguh dan siap kerja di BPOM berlanjut ke Makassar Kamis (04/10). Job fair yang diadakan di Universitas Ha...
SelengkapnyaBuktikan Komitmen, BPOM Lakukan Resertifikasi ISO 9001:2015
04 Oct 2018 Dilihat 3729 kali Kerjasama dan HumasJakarta – Untuk meningkatkan pelayanan kepada masyarakat dalam rangka pelaksanaan pengawasan obat dan makanan, diperlukan penerapan Sistem Manajemen Mutu ISO 9001: 2015 di BPOM. Hal ini dilakukan agar pelaksanaan p...
Selengkapnya
Pengumuman Seleksi Terbuka JPT Pratama (Eselon II) Badan Pengawas Obat dan Makanan 2018
04 Oct 2018 Dilihat 5588 kali Pengumuman 4PENGUMUMANNomor: KP.04.011.2.242.10.18.4858SELEKSI TERBUKA JABATAN PIMPINAN TINGGI PRATAMA (ESELON II)BADAN PENGAWAS OBAT DAN MAKANAN TAHUN 2018 Dalam rangka pelaksanaan amanat Undang-Undang Nomor 5 Tahun 2014 ten...
SelengkapnyaBPOM Hadir, ringankan duka masyarakat Palu, Sigi dan Donggala
04 Oct 2018 Dilihat 3174 kali Kerjasama dan HumasJakarta – Selasa (28/09), Gempa bumi dengan kekuatan 7.4 skala richter yang mengguncang Sulawesi Tengah dan menimbulkan Tsunami dan Likuifaksi di Palu-Donggaka dan sekitarnya, telah menyebabkan berbagai infrastrukt...
Selengkapnya
Kerjasama BPOM dan Rumah Sakit dalam Pemetaan Kasus Keracunan di Indonesia
03 Oct 2018 Dilihat 5520 kali Pusat Data dan Informasi Obat dan MakananBadan Pengawas Obat dan Makanan melalui Pusat Data dan Informasi Obat dan Makanan melaksanakan pertemuan Perkuatan Koordinasi Lintas Sektor Kegiatan Pemetaan Kasus Keracunan di Indonesia pada Selasa, 2 Oktober 2018 di Ja...
Selengkapnya
Job Fair CPNS 2018 Sambangi Kota Pahlawan
02 Oct 2018 Dilihat 2725 kali Kerjasama dan HumasSurabaya - Melanjutkan roadshow Job Fair Penerimaan CPNS 2018, BPOM hadir di Universitas Airlangga, Surabaya (02/10). Terik matahari Kota Pahlawan siang itu, tak menyurutkan animo pengunjung baik alumni yang berdatangan ...
Selengkapnya
Memperkuat Pengawasan Dengan Manajemen Sampel Obat dan Makanan
02 Oct 2018 Dilihat 2115 kali Kerjasama dan HumasJakarta - Sadar akan pentingnya perkuatan pengawasan, BPOM menyelenggarakan Rapat Koordinasi Pusat dan Balai POM Dalam Manajemen Sampling Obat dan Makanan. Koordinasi manajemen sampling ini dilakukan mengingat BPOM saat ...
Selengkapnya